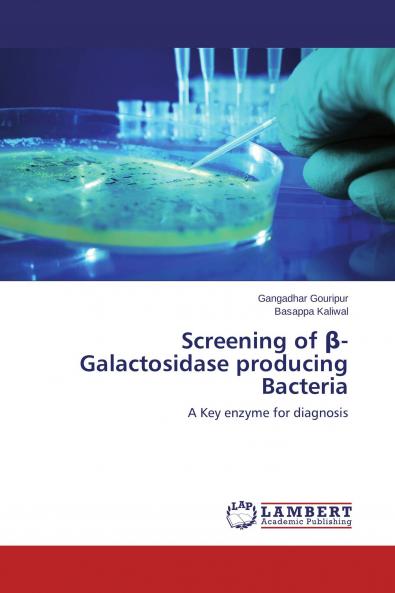
Screening of ��-Galactosidase producing Bacteria

English
Paperback
₹6824
(All inclusive*)
Delivery Options
Please enter pincode to check delivery time.
*COD & Shipping Charges may apply on certain items.
Review final details at checkout.
Looking to place a bulk order? SUBMIT DETAILS
About The Book
Description
Author
The enzyme β-galactosidase has tremendous potential in research and application in various fields like food bioremediation biosensor diagnosis and treatment of disorders. The sources of the β-galactosidase are microorganisms plants and animals. β-galactosidase producing bacteria was isolated from milk and milk products. Bacteria were tested for their ability to hydrolyze 5- bromo-4-chloro-3-indolyl-β-D-galactosidase (X-Gal) and O-nitro phenyl-β-D-galactopyranoside (ONPG). Further it was characterized by biochemical and molecular methods.
Delivery Options
Please enter pincode to check delivery time.
*COD & Shipping Charges may apply on certain items.
Review final details at checkout.
Details
ISBN 13
9783659773037
Publication Date
-04-09-2015
Pages
-180
Weight
-252 grams
Dimensions
-150x220x9.85 mm